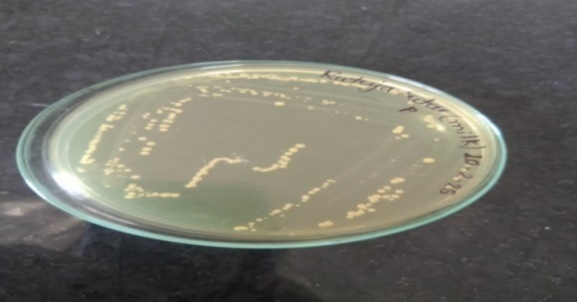

Department of Biotechnology and Microbiology, Smt. Kasturbai Walchand College of Arts and Science, Sangli-416416, (M. S.) India
*Corresponding author: Vandana Ramchandra Dongare; *Email: gavadepj@gmail.com
Received: 15 Nov 2025, Revised and Accepted: 21 Jan 2026
ABSTRAC
Objective: The present study aimed to formulate a novel non-dairy probiotic beverage using watermelon juice as a fermentation substrate and to evaluate its physicochemical and functional attributes.
Methods: Watermelon, a widely consumed fruit rich in natural sugars, vitamins, and antioxidants, was selected as an ideal substrate for probiotication. Lactic acid bacteria (LAB) were isolated from milk and characterized through morphological and biochemical analyses. The identified LAB strains were subsequently inoculated into pasteurized watermelon juice and subjected to controlled fermentation. The pH, turbidity, and titratable acidity of the fermenting substrate were monitored on the 1st, 4th, 7th, and 10th d, while viable cell counts (CFU/ml) were assessed on the 4th d. The fermented probiotic juice was further evaluated for antimicrobial efficacy against representative Gram-positive (Staphylococcus aureus) and Gram-negative (Escherichia coli, Salmonella typhi) pathogens.
Results: Watermelon juice, rich in natural sugars and bioactive compounds, was used as a substrate for probiotication using lactic acid bacteria (LAB) isolated from milk. The identified LAB strains were inoculated into pasteurized watermelon juice and fermented under controlled conditions. Fermentation resulted in a progressive decrease in pH with a corresponding increase in titratable acidity, confirming active lactic acid production. Viable LAB counts exceeded the minimum therapeutic level of 3.5×10⁷ CFU/ml, indicating effective probiotic survival. The probioticated juice exhibited significant antimicrobial activity against Staphylococcus aureus, Escherichia coli, and Salmonella typhi. Overall, fermentation enhanced the functional quality of watermelon juice, establishing it as a promising non-dairy probiotic beverage suitable for lactose-intolerant and vegan consumers.
Conclusion: The findings demonstrate that watermelon juice fermented with milk-derived lactic acid bacteria constitutes a viable and effective base for developing a health-promoting non-dairy probiotic beverage.
Keywords: Probiotics, Watermelon, Lactic acid bacteria
© 2026 The Authors. Published by Innovare Academic Sciences Pvt Ltd. This is an open access article under the CC BY license (https://creativecommons.org/licenses/by/4.0/)
DOI: https://dx.doi.org/10.22159/ijpps.2026v18i3.57387 Journal homepage: https://innovareacademics.in/journals/index.php/ijpps
The term probiotic, originating from the Greek meaning “for life,” was first introduced by Lilley and Stillwell. Probiotics are defined as live microorganisms which, when administered in adequate amounts, confer significant health benefits to the host [1–3]. Fruit juices, being naturally abundant in fermentable sugars, serve as excellent substrates for the cultivation of probiotic lactic acid bacteria (LAB). Their intrinsic nutritional richness makes them highly suitable for the development of functional beverages. Recent studies have increasingly emphasized the potential of fruit juices as effective carriers for probiotic delivery. Furthermore, fruit juices commonly fortified with vitamins and minerals for general wellness exhibit enhanced therapeutic benefits when combined with probiotics, ensuring optimal realization of their health-promoting properties [4].
Lactic acid bacteria (LAB) are Gram-positive microorganisms widely distributed in nature and are renowned for their ability to produce lactic acid through homofermentative or heterofermentative metabolic pathways. Among these, species of Lactobacillus are particularly notable for their functional attributes, including the degradation of carbohydrates, proteins, and lipids. This bioconversion process enhances the bioavailability of vital nutrients such as minerals, amino acids, and vitamins essential for human and animal health. Additionally, LAB exhibit strong antagonistic activity against various spoilage and pathogenic microorganisms through the production of organic acids, hydrogen peroxide, diacetyl, bacteriocins, and other antimicrobial metabolites [5]. Owing to these beneficial properties, LAB are among the most widely utilized probiotics in food-based applications.
Incorporating LAB into fruit juices not only improves their functional qualities but also enhances their overall nutritional value. Watermelon juice, in particular, is an exceptional substrate due to its rich composition of bioactive compounds. It contains substantial amounts of lycopene, along with vitamins A, B-complex, and C, as well as important minerals. Regular consumption of watermelon juice is associated with increased plasma levels of lycopene and β-carotene, potent antioxidants known for their protective roles against cardiovascular diseases and cancers such as prostate, bladder, and cervical malignancies [6]. Fruits and vegetables are inherently free of dairy allergens, making them suitable for a broader consumer population, including individuals with lactose intolerance or those following plant-based diets. Their natural abundance of vitamins, minerals, dietary fiber, and antioxidants further strengthens their appeal as carriers of functional ingredients. In recent years, there has been growing scientific interest in the development of fruit-based nutritional beverages enriched with probiotic and prebiotic components. Given their inherent nutritional density, sensory acceptability, and favorable perception among consumers, fruit juices are regarded as ideal vehicles for delivering probiotics to the gastrointestinal tract while circumventing issues associated with dairy-based matrices [7, 8].
Watermelon, compared to dairy substrates, offers multiple advantages for probiotic fermentation. It is naturally rich in antioxidants, particularly phenolic compounds, and contains bioactive amino acids such as citrulline and arginine, which contribute to various physiological benefits. Being cholesterol-free, lactose-free, and plant-based, watermelon juice is especially suitable for individuals with dietary restrictions. Its high natural sugar content and near-neutral pH create a conducive environment for the growth and survival of probiotic bacteria, making it an excellent candidate for nondairy probiotic beverage formulation.
Fresh watermelon (Citrullus lanatus) fruits were used as the raw material for fruit juice extraction.
Chemicals and reagents
Nutrient agar, biochemical reagents for the characterization of lactic acid bacteria, 2, 6-dichlorophenol indophenol (DCIP), sodium acetate, de Man, Rogosa and Sharpe (MRS) medium were used in the study. All chemicals and reagents employed were of analytical reagent (AR) grade and were purchased locally.
Methods
Isolation of lactic acid bacteria
Lactic acid bacteria (LAB) were isolated from a milk sample using standard microbiological procedures. Briefly, 1–2% of the milk inoculum was transferred into 50 ml of sterile MRS broth and incubated at 37 °C for 24 h under anaerobic conditions. The development of turbidity after incubation indicated active bacterial growth. A loopful of the culture was subsequently streaked onto sterile MRS agar plates using the four-quadrant streaking technique under aseptic conditions. The plates were incubated at 37 °C for 24 h. Following incubation, well-defined colonies were streaked onto fresh MRS agar plates to obtain purified, isolated colonies for further analysis [9, 10].
Identification of lactic acid bacteria
Identification of the lactic acid bacteria was performed based on their morphological characteristics and standard biochemical tests.
Morphological characterization
Gram staining of the isolate was performed using Hucker’s modification method [11]. Motility was assessed by the hanging drop technique. The isolate was further characterized through a series of biochemical assays, including the motility test, catalase test, oxidase test [12], amylase activity test, nitrate reduction test, gelatin hydrolysis test, lysine decarboxylation, hydrogen sulfide (H₂S) production test, and carbohydrate utilization profiling. The biochemical characteristics obtained were compared with the descriptions provided in Bergey’s Manual of Systematic Bacteriology [9] for confirmation of the isolate.
Preparation of substrate
Watermelons were procured from a local vegetable market and thoroughly washed under running tap water, followed by rinsing with distilled water and blot-drying. The seeds were manually removed from the pulp. The fruit pulp was homogenized using a laboratory grinder to obtain juice, which was then filtered through sterile muslin cloth. The resulting juice was subsequently sterilized and used as the substrate for further experimental studies.
Probiotication of watermelon juice
The given isolated microorganism i. e culture were grown at 37℃ separately for 24 h in de Man, Rogosa and Sharpe (MRS) broth.
Inoculation of inoculum in to substrate
A 2% inoculum prepared from a 24 h old culture incubated at 37 °C was added to the substrate for fermentation. Fermentation was carried out in 250 ml Erlenmeyer flasks, each containing 150 ml of sterilized watermelon juice, followed by the addition of the 2% inoculum. The inoculated juice was incubated at 37 °C for 48 h to allow fermentation to proceed. The fermented samples were subsequently used for biochemical analyses [8].
Determination of physicochemical parameters
pH
The pH measurement was conducted to assess the acidity and alkalinity of the fermented product. The pH of the fermented juice was recorded on the 1st, 4th, 7th, and 10th d of storage. For each measurement, the pH electrode was immersed in 20 ml of the sample, and the pH value was directly read from the pH meter. Prior to analysis, the pH meter was calibrated using standard buffer solutions to ensure accuracy.
Turbidity
The transmittance and absorbance of watermelon juice is measured using UV Spectrophotometer at 540 nm before and after probiotication.
Titratable acidity (TTA)
Total titratable acidity (TTA) was determined following the AOAC (2010) method. Briefly, 10 ml of the sample was transferred into a beaker, and three drops of phenolphthalein indicator were added. The sample was titrated with 0.1 M NaOH until a faint pink endpoint persisted for at least one minute against a white background. The volume of NaOH used was recorded and subsequently applied to calculate the TTA, which was expressed as a percentage of lactic acid. The TTA was determined using the following equation [13]:
Titratable acidity (%) = (V×N×Eq. wt. of lactic acid/Volume of sample)×100.
Viability of lactic acid bacterial strains in fermented watermelon juice (4th day)
The viable cell count of the fermented juice was assessed on the 4th day of fermentation and expressed as colony-forming units (CFU). The samples were serially diluted and plated onto MRS agar using the micro-drop technique [7]. The plates were incubated at 37 °C for 48 h, after which colonies were enumerated. The viable cell count was calculated and reported as CFU/ml.
Antibacterial activity
The antibacterial activity of the probioticated substrate was evaluated against selected pathogenic microorganisms. Standard reference strains of Escherichia coli, Salmonella typhi, Bacillus spp., and Staphylococcus aureus were procured from the Microbial Type Culture Collection (MTCC), Chandigarh, India, and used for antimicrobial assays. The test organisms Escherichia coli, Salmonella typhi, Bacillus spp., and Staphylococcus aureus were cultured in nutrient broth at 37 °C for 24 h. Bacterial suspensions were adjusted to a turbidity equivalent to 0.5 McFarland standard (approximately 1.5×10⁸ CFU/ml). Actively growing cultures (100 µl**) of each test organism were uniformly spread onto nutrient agar plates. Wells of 6 mm diameter were aseptically created using a sterile cork borer. Aliquots of the probioticated substrate (50, 75, and 100 µl**) were dispensed into the wells. The plates were initially kept at 4 °C for 15 min to facilitate diffusion of the test material into the agar, followed by incubation at 37 °C for 24 h. After incubation, the diameter of the inhibition zone surrounding each well was measured (in centimeters) from the center of the well [4].
Fresh watermelon (Citrullus lanatus) fruits were successfully processed to obtain clear, naturally sweet juice, which served as the base substrate for subsequent analyses.
Isolation of Lactobacillus
For the isolation of Lactobacillus spp., the milk sample was spread onto selective MRS agar. Following incubation, distinct bacterial colonies were observed on the plates, as shown in fig. 1.
Fig. 1: Bacterial colonies observed on MRS plates
The bacterial colonies isolated on MRS agar, as depicted in fig. 1, were characterized based on their morphological features and biochemical profiles. The corresponding results are presented in table 1 and table 2.
Table 1: Morphological characteristic of isolated bacteria
| Characteristic | Results |
| Size | 3 mm |
| Shape | Circular |
| Margin | Entire |
| Colour | White |
| Consistancy | Sticky |
| Elevation | Raised |
| Opacity | Opaque |
| Surface | Smooth |
| Gram staining | Gram Positive |
| Motility | Non motile |
Shape, margin, colour, elevation, surface, opacity, and consistency were determined by visual examination under adequate illumination. After incubation at 37 C for 24 h, on MRS agar plate, the morphological result was recorded as shown table 1.

Fig. 2: Gram-stained morphology of the isolated bacteria observed under oil immersion (100× objective; Total magnification = 1000×; Scale bar = 10 µm). The colonies tested positive in Gram staining, supporting their classification as Lactobacillus sp. as shown in fig. 2
Table 2: Biochemical test for the isolated LAB
| S. No. | Biochemical test | Results |
| 1 | Oxidase test | -ve |
| 2 | Catalase test | -ve |
| 3 | Indole test | -ve |
| 4 | Methyl Red test | +ve |
| 5 | Vogous Proskauer test- | -ve |
| 6 | Citrate Utilization test | -ve |
| 7 | Amylase test | -ve |
| 8 | Gelatin test | -ve |
| 9 | Lysine Decarboxylation test | -ve |
| Carbohydrate utilization test | ||
| 11 | Glucose | +ve |
| 12 | Sucrose | -ve |
| 13 | Lactose | +ve |
| 14 | Maltose | +ve |
| 15 | Galactose | +ve |
| 16 | Fructose | -ve |
| 17 | Mannitol | -ve |
| 18 | Arabinose | -ve |
| 19 | Xylose | +ve |
(+ve)-Positive, (-ve)-Negative
Morphological and biochemical tests were performed for the characterization of the isolated bacteria, and the outcomes are summarized in table 1 and table 2. By comparing these results with Bergey’s Manual of Bacteriology, the isolate was identified as a member of the Lactobacillus genus.
Probiotication of watermelon juice
The process of probiotication of watermelon juice was successfully carried out using isolated lactic acid bacteria from milk sample. The fresh juice appeared bright red in color, while the probioticated juice exhibited a lighter, whitish-pink appearance due to the growth of Lactobacillus sp. and metabolic activity during fermentation. The change in color and turbidity indicates microbial activity, acid production, and successful transformation of watermelon juice into a probiotic beverage.
The biochemical and microbiological changes in watermelon juice during fermentation with lactic acid bacteria were monitored at regular intervals.
PH, Turbidity, and Acidity of watermelon juice during fermentation
The results (table 1) show that the pH of the juice decreased slightly during fermentation, indicating acid production by lactic acid bacteria. The initial pH (3.515 on day 1) decreased to 3.174 by the 4th day and stabilized around 3.391–3.515 by the 10th day. Turbidity values gradually decreased from 2.151 on day 1 to 1.035 on the 10th day, which suggests microbial utilization of nutrients and metabolic activity. Acidity showed a gradual increase from 0.0189% on day 1 to 0.0315% on the 7th day, reflecting lactic acid production, followed by a slight stabilization at 0.0306% on day 10.
Viable cell count of lactic acid bacteria on 4th day (CFU/ml)
The viable cell count of lactic acid bacteria as shown in table 5 reached 3.5×107 CFU/ml on the 4th day, confirming active growth and proliferation of probiotic organisms. This high cell density indicates the successful fermentation and establishment of a probiotic population in watermelon juice.
Table 3: The results of pH, Turbidity and Acidity
| pH, Turbidity and acidity | |||
| Day | pH | Turbidity | Acidity |
| 1st day | 3.515 | 2.151 | 0.0189% |
| 4th day | 3.174 | 1.225 | 0.0270% |
| 7th day | 3.515 | 1.120 | 0.0315% |
| 10th day | 3.391 | 1.035 | 0.0306% |
Table 4: Antibacterial activity of fermented probiotic watermelon juice
| Microorganisms | Zone of inhibition(cm) | ||
| 50µl | 75µl | 100µl | |
| Esherichia coli | No Zone | 1.0±0.21 | 1.3±0.22 |
| Salmonella typhi | No Zone | No Zone | 1.1±0.15 |
| Bacillus | No Zone | No Zone | 1.3±0.22 |
| Staphylococcus aureus | No Zone | No Zone | 1.2±0.25 |
NZ-No Zone, value are expressed as mean±SEM (n=3) All the values showed significant difference from solvent control at p<0.05.
Table 5: Viable cell count of lactic acid bacteria on 4th day (CFU/ml)
| Day | CFU(colony forming unit) |
| 4th day | 3.5×107CFU/ml |
When the lactic acid bacteria from milk sample isolated on selective MRS media [10], which are typically Gram-positive, non-motile, and form off-white colonies. The biochemical test revealed that utilization of glucose, lactose, maltose, galactose and xylose and showing methyl red test positive. Based on morphological and biochemical test the isolated bacteria belonged to the lactic acid bacteria group.
Probiotication is a process of inoculating beneficial microorganisms (mostly lactic acid bacteria) into a liquid substrate to manufacture functional beverages, which subsequently adds market value due to the various health benefits of probiotics [14]. The successful growth of these isolates in watermelon juice demonstrates their ability to survive and adapt in a fruit-based substrate, which is essential for developing non-dairy probiotic products.
Watermelon juice, being rich in sugars, amino acids (citrulline, arginine), and antioxidants [15, 16], a favorable environment for LAB growth and fermentation. The decrease in pH and increase in acidity during fermentation further support the metabolic activity of LAB, indicating their potential role in improving the nutritional and functional quality of the juice. These findings align with earlier studies reporting that fruit juices, especially watermelon, can act as promising carriers for probiotics, offering an alternative to traditional dairy-based products for individuals with lactose intolerance or milk allergies. Overall, the study demonstrates that milk-isolated LAB can be effectively utilized for the fermentation of watermelon juice to produce a probiotic-rich functional beverage
Fermentation is the metabolism of organic substrate by microbes like lactic acid bacteria to obtain desirable biochemical changes. As a result of their prevalence and effectiveness in fermented foods lactic acid bacteria (LAB) are the most significant strains used for controlled fermentation LABs are divided into two groups depending on their fermentation pathway. Lactococcus and streptococcus yield two lactate from one glucose molecule. Heterofermentative such as Leuconostoc and Weissella produce one lactate, ethanol and carbon dioxide from one molecule of glucose. In addition, LAB produce small organic compounds that give the aroma and flavor to fermented products. LAB contribute to enrichment of the human dietary through development of a wide diversity of flavors, aromas and textures in food through the fermentation process and enrichment of food substrate biologically with protein, essential amino acids, essential fatty acids and vitamin [13]. The fermentation of watermelon juice with lactic acid bacteria resulted in noticeable changes in physicochemical parameters such as pH, turbidity, and titratable acidity over the 10 d storage period. Fermentation promotes changes in nutritional value, sensory characteristics, and microbial safety of products. This technology has important advantages due to the improvement of food taste, food safety, and shelf life, with an increase in its nutritional properties [17]. The pH of the fermented juice fluctuated slightly during the process, ranging from 3.515 on the 1st day, decreasing to 3.174 by the 4th day, and then showing slight increases on subsequent days (3.515 on the 7th day and 3.391 on the 10th day). The initial reduction in pH corresponds to the production of organic acids, primarily lactic acid, which is typical of LAB fermentation. The later stabilization of pH may be attributed to buffering components present in watermelon juice or reduced microbial activity after extended fermentation.
Turbidity gradually decreased from 2.151 on day 1 to 1.035 on day 10. The reduction in turbidity could be due to sedimentation of suspended particles, microbial utilization of soluble nutrients, and clarification of the juice during prolonged fermentation. A similar trend has been reported in fruit-based probiotic beverages, where fermentation extended leads to clearer juice appearance.
Acidity increased steadily from 0.0189% on the 1st d to 0.0315% by the 7th d, before slightly reducing to 0.0306% on the 10th d. This increase reflects the accumulation of lactic acid as a metabolic by-product of LAB activity. The slight decline on the 10th day might suggest a slowdown in microbial metabolism or possible utilization of acids for secondary metabolic processes.
Overall, these results indicate that the LAB isolates were metabolically active in watermelon juice, contributing to acid production and fermentation-associated changes. The observed patterns of decreasing pH, increasing acidity, and declining turbidity confirm successful fermentation and demonstrate the potential of watermelon juice as a suitable substrate for probiotic LAB growth. These findings are consistent with previous studies that highlight the feasibility of using fruit juices as non-dairy carriers for probiotic delivery.
The genera Lactobacillus, Pediococcus and Lactococcus belong to the lactic acid bacteria (LAB), and the strains of these genera are frequently used on a large scale in the production and preservation of many foods or as probiotics for human and animals. LAB with probiotic activity are generally enteric flora and are believed to play a beneficial role in the ecosystem of the human gastrointestinal (GI) tract [18]. The viable cell count of lactic acid bacteria (LAB) in fermented watermelon juice reached 3.5×107CFU/ml on the 4th day of fermentation, indicating robust microbial proliferation and active fermentation. This high cell density demonstrates that the watermelon juice provided a favorable environment rich in fermentable sugars and nutrients that supported LAB growth.
The internationally endorsed definition of probiotics is live microorganisms that, when administered in adequate amounts, confer a health benefit on the host. Major probiotic mechanisms of action include enhancement of the epithelial barrier, increased adhesion to intestinal mucosa, and concomitant inhibition of pathogen adhesion, competitive exclusion of pathogenic microorganisms, production of anti-microorganism substances and modulation of the immune system also contribute to the reinforcement of the mucosal barrier. Taking into consideration their definition the number of microbial species which may exert probiotic properties is impressive. Some of the most important bacteria L. acidophilus, L. casei, L. crispatus, L. gallinarum, L. johnsonii, B. adolescentis, B. bifidum, B. infantis [19, 20]. Probiotics can produce neurotransmitters in the gut through the gut-brain axis. Specific probiotic stains can modulate the serotonin, gamma-aminobutyric acid (GABA), and dopamine levels, affecting mood, behavior, gut motility, and stress-related pathways [21].
Fruit and vegetables include polyphenol compounds, which are good providers of vitamins and minerals and have a very appealing profile for people of all ages. Some probiotic lactic acid bacteria (LAB) can ferment slightly acidic plant and vegetable-derived substances, making them a potential probiotic source. The nutritional components of fruit and vegetables are moderators of metabolic simulators and detoxifiers of carcinogens [22]. Lactic acid bacteria (LAB) are commonly found in fermented milk products and are well known for their probiotic potential and health-promoting effects. In this study, LAB was isolated from milk samples due to their proven safety and strong fermentative ability. Watermelon juice was selected as a fermentation substrate because it is rich in sugars, vitamins, and bioactive compounds, providing a suitable environment for bacterial growth. Moreover, using watermelon juice as a non-dairy medium allows the development of a functional, lactose-free probiotic beverage that can be consumed by a wider population, including individuals with dairy allergies or lactose intolerance.
The present study demonstrated the successful development of a non-dairy probiotic beverage using watermelon juice fermented with lactic acid bacteria isolated from milk. The isolated LAB exhibited good adaptability and viability in the watermelon substrate, maintaining a high viable cell count above the therapeutic level (3.5×107CFU/ml) throughout fermentation. A notable decrease in pH and increase in titratable acidity confirmed active lactic acid production. The fermented juice showed significant antimicrobial activity against both Gram-positive and Gram-negative pathogenic bacteria, including Staphylococcus aureus, Escherichia coli, and Salmonella typhi. Overall, the study confirms that watermelon juice can serve as a promising alternative substrate for producing functional, lactose-free probiotic drinks with enhanced nutritional and health-promoting properties.
Rutuja Sutar conceived and designed the study and conducted the experimental work. Vandana Ramchandra Dongare and Suryakant Sukumar Wadkar contributed to the writing and critical revision of the manuscript. All authors have read and approved the final version of the manuscript. The authors express their sincere gratitude to the Principal of Smt. Kasturbai Walchand Arts and Science College, Sangli, for providing the necessary facilities and support.
Nil
LAB-Lactic Acid Bacteria, CFU-Colony Forming Unit, MRS-DeMan, Rogosa and Sharpe, DCIP-2, 6-dichlorophenol indophenol.
Rutuja Sutar performed the experimental work and data collection. Vandana Ramchandra Dongare conceptualized the study, supervised the research work, analyzed the data, and drafted and revised the manuscript. Suryakant Sukumar Wadkar provided departmental facilities and instrumental support required for the completion of the study. All authors read and approved the final manuscript.
The authors have no conflicts of interest to declare
Sarita B, Samadhan D, Hassan MZ, Kovaleva EG. A comprehensive review of probiotics and human health-current prospective and applications. Front Microbiol. 2025;15:1487641. doi: 10.3389/fmicb.2024.1487641, PMID 39834364.
Nagpal R, Kumar A, Kumar M, Behare PV, Jain S, Yadav H. Probiotics their health benefits and applications for developing healthier foods: a review. FEMS Microbiol Lett. 2012;334(1):1-15. doi: 10.1111/j.1574-6968.2012.02593.x, PMID 22568660.
Merenstein D, Pot B, Leyer G, Ouwehand AC, Preidis GA, Elkins CA. Emerging issues in probiotic safety: 2023 perspectives. Gut Microbes. 2023;15(1):2185034. doi: 10.1080/19490976.2023.2185034, PMID 36919522.
Mohan G, Ponnusamy G, Veluswamy K, Santhiya N, Sundarrajan A. Probiotication of fruit juices by Lactobacillus acidophilus. Int J Adv Biotechnol Res. 2013;4(1):72-7.
Gill PK. Lactic acid bacteria as probiotics: current status and future prospects. AJMAB. 2023;8(2):120-39. doi: 10.56557/AJMAB/2023/v8i28424.
Marie Michel CA, Pierre Valery NK, Christine EA, Amah Salomee KG, Avit Maxwell BG. Physicochemical microbiological and sensory characterization of juice produced from watermelon (Citrullus lanatus) consumed in Cote d’Ivoire. SJBR. 2020;5(11):335-42. doi: 10.36348/sjbr.2020.v05i11.009.
Lani MN, Mohd Mangsor NH, Sharifudin SA, Abdullah WZ, MohdIsa NS, Jamzuri MN. Chemical and microbiological analysis of fermented probiotic watermelon juice. Food Res. 2022;6(3):324-34. doi: 10.26656/fr.2017.6(3).402.
Sivudu SN, Umamahesh K, Reddy OV. A comparative study on probiotication of mixed watermelon and tomato juice using probiotic strains of Lactobacilli. Int J Curr Microbiol Appl Sci. 2014;3(11):977-84.
Narwade R, Kasare J, Choudhary R. Isolation screening and characterization of Lactobacilli from cow milk. Int J Agric Innov Res. 2015;3(6):1736-42.
Rai A, Singh SK. Probiotication of vegetable juice by Lactobacillus acidophilus. Indian J Appl Pure Biol. 2020;35(2):159-69.
Hucker GJ. A new modification and application of the gram stain. J Bacteriol. 1921;6(4):395-7. doi: 10.1128/jb.6.4.395-397.1921, PMID 16558927.
Bhattacharyya S. Overview on old and new biochemical test for bacterial identification. JSCRI. 2023;6(5):1-11. doi: 10.31579/2690-1897/163.
Adesokan I. Production of functional fruit juice from water melon (Citrullus lanatus) by fermentation of lactic acid bacteria. World J Adv Sci Technol. 2023;3(2):21-6. doi: 10.53346/wjast.2023.3.2.0064.
Mojikon FD, Kasimin ME, Molujin AM, Gansau JA, Jawan R. Probiotication of nutritious fruit and vegetable juices: an alternative to dairy-based probiotic functional products. Nutrients. 2022;14(17):3457. doi: 10.3390/nu14173457, PMID 36079714.
Dike OG, Ferdinand C, Abdullahi MA, Mustapha BO, Ayoola BO, Arabambi FD. Comparative estimation of ascorbic acid (Vitamin C) in Sweet-melon watermelon and Cucumber. Dutse J Pure Appl Sci. 2024;10(3c):304-12. doi: 10.4314/dujopas.v10i3c.29.
Begum T, Islam ZK, Rana Siddiki MS, Habib R, Rashid HU. Preparation of fermented beverage from whey-based watermelon (Citrullus lanatus) juice. Asian J Dairy Food Res. 2019;38(4):301-6. doi: 10.18805/ajdfr.DR-150.
Pinto T, Vilela A, Cosme F. Chemical and sensory characteristics of fruit juice and fruit fermented beverages and their consumer acceptance. Beverages. 2022;8(2):33. doi: 10.3390/beverages8020033.
Serrano Nino JC, Solis Pacheco JR, Gutierrez Padilla JA, Cobian Garcia A, Cavazos Garduno A, Gonzalez Reynoso O. Isolation and identification of lactic acid bacteria from human milk with potential probiotic properties. J Food Nutr Res. 2016;4(3):170-7. doi: 10.12691/jfnr-4-3-7.
Bagkar MY, Ghadge PB, Shahapurkar AA, Shahapurkar MA. A review on the potential health benefits and various applications of probiotics. World J Pharm Res. 2023;10:76-83. doi: 10.20959/wjpr202310-28108.
Maftei NM, Raileanu CR, Balta AA, Ambrose L, Boev M, Marin DB. The potential impact of probiotics on human health: an update on their health-promoting properties. Microorganisms. 2024;12(2):234. doi: 10.3390/microorganisms12020234, PMID 38399637.
Latif A, Shehzad A, Niazi S, Zahid A, Ashraf W, Iqbal MW. Probiotics: mechanism of action health benefits and their application in food industries. Front Microbiol. 2023;14:1216674. doi: 10.3389/fmicb.2023.1216674, PMID 37664108.
Rahman S, Emon DD, Toma M, Nupur A, Karmoker P, Iqbal A. Recent advances in the probiotication of fruit and vegetable juices. J Adv Vet Anim Res. 2023;10(3):522-37. doi: 10.5455/javar.2023.